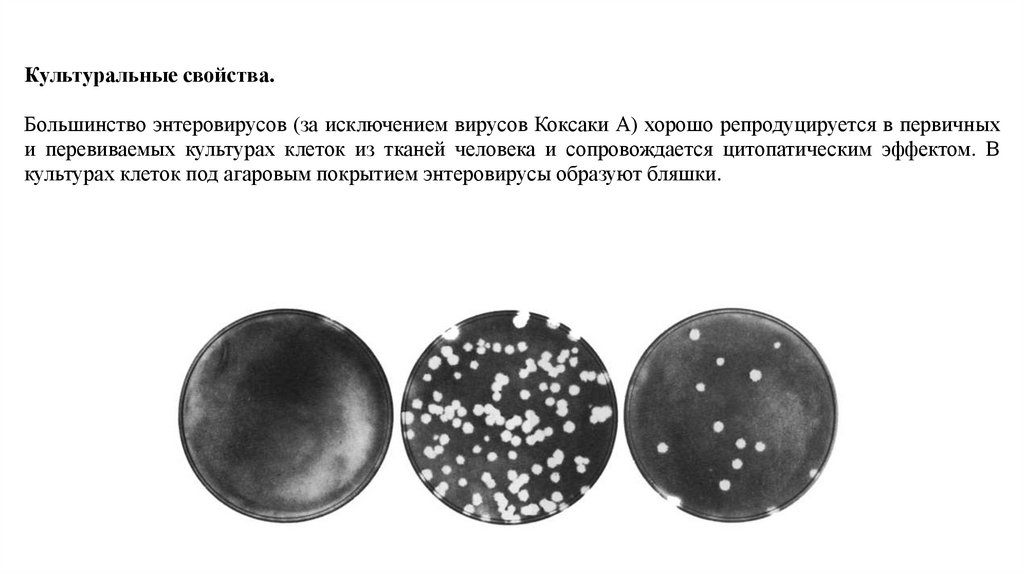

Similar presentations:
Полиомиелит
1.
Полиомиелитсемейство Picornaviridae, род Enterovirus
2.
Морфология.РНК-содержащий вирус
сферическая форма, диаметр 20-30 нм,
состоят из одноцепочечной плюс-нитевой
РНК и капсида с кубическим типом
симметрии.
Вирус
не
имеет
суперкапсидной
оболочки.
В составе нет углеводов и липидов
3.
4.
Культуральные свойства.Большинство энтеровирусов (за исключением вирусов Коксаки А) хорошо репродуцируется в первичных
и перевиваемых культурах клеток из тканей человека и сопровождается цитопатическим эффектом. В
культурах клеток под агаровым покрытием энтеровирусы образуют бляшки.
5.
АГ - структура.Различают 3 серотипа внутри вида: 1, 2, 3, не вызывающие перекрестного иммунитета
6.
7.
Патогенез.8.
Клиническая картина.Инкубационный период продолжается в
среднем 7—14 дней.
Различают 3 клинические формы
полиомиелита:
1) паралитическую,
2) менингеальную (без параличей),
3) бессимптомную,
4) абортивную (легкая форма).
Заболевание начинается с повышения
температуры тела, общего недомогания,
головных болей, рвоты, болей в горле.
Полиомиелит нередко имеет двухволновое
течение, когда после легкой формы и
наступившего значительного улучшения
развивается тяжелая форма болезни.
9.
Периоды заболеванияПрепаралитический
Паралитический
1 – 6 дней
Лихорадочные явления (до 39 градусов)
Катаральные явления и дисфункция кишечника
Боли в позвоночнике
24 часа – 3 дня
«утренний паралич», парез – паралич, арефлекция
Восстановительный
До 3х лет
Появления произвольных движений в пораженной
конечности
Остаточные явления
(Резидуальный)
Свыше 3х лет
Ранее утраченные функции не восстанавливаются
или восстанавливаются частично.
Атрофия мышц
Деформация конечностей
10.
Диагностика.Материалом для исследования служат кал, отделяемое носоглотки, при летальньгх исходах —
кусочки головного и спинного мозга, лимфатические узлы.
Идентифицируют (типируют) выделенный вирус с помощью типоспецифических сывороток в
реакции нейтрализации в культуре клеток или ИФА, а также ПЦР
Важным является отличить «дикий» штамм от вакцинного.
Количесвто антител определяют методом «парных сывороток», а так же реакцией Манчини.
11.
Лечение.Профилактика.
Сыворотка
1) Парентеральная вакцина инактивированная
Противовирусная неспецифическая
вакцина Дж. Солка (Вакцина Солка)
терапия
2) Пероральная живая культуральная вакцина
Симптоматическая терапия
на основе трех серотипов штаммов Сэбина
+ физиотерапия
(вакцина Сэбина)
3) Современные БиоВак Полио и Имовакс, а так
же другие

medicine
medicine








